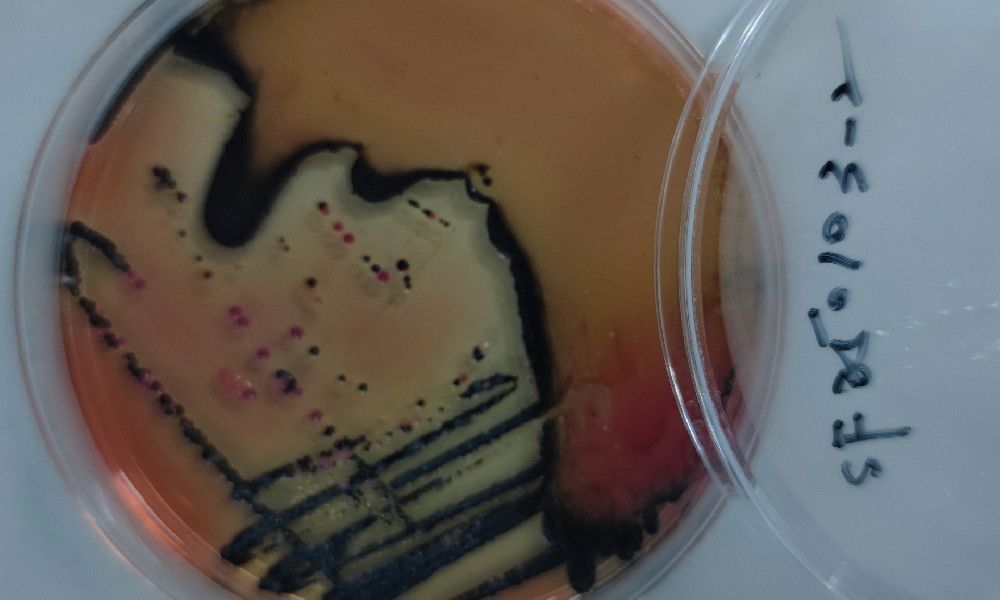

食品安全,是懸于每一家食品企業(yè)頭頂?shù)倪_摩克利斯之劍,更是維系消費者信任的基石。在這條生命線上,微生物污染的防控?zé)o疑是一場與看不見的敵人展開的、分秒必爭的攻防戰(zhàn)。任何環(huán)節(jié)的疏漏,都可能引發(fā)一場導(dǎo)致產(chǎn)品召回、品牌聲譽受損甚至法律訴訟的“完美風(fēng)暴”。作為深耕食品工業(yè)消毒領(lǐng)域多年的專業(yè)技術(shù)服務(wù)商,梵通生物深知這場戰(zhàn)役的復(fù)雜性與艱巨性。我們依托前沿的精準(zhǔn)檢測技術(shù)與科學(xué)的全流程干預(yù)方案,致力于為廣大食品企業(yè)構(gòu)建一道從源頭到終端、堅不可摧的微生物污染防控體系,助力客戶在激烈的市場競爭中,實現(xiàn)產(chǎn)品安全與經(jīng)濟效益的雙贏。
第一篇章:潛伏的危機——食品微生物污染的全鏈條風(fēng)險透視
微生物污染如同幽靈,潛伏于食品生產(chǎn)供應(yīng)鏈的每一個角落,其威脅形式多樣,且往往在造成實質(zhì)損害前難以察覺。我們必須對其進行系統(tǒng)性的全鏈條解析,才能做到有的放矢。
源頭端:污染的“種子”
原料是食品的起點,也是污染風(fēng)險的第一道關(guān)口。土壤中可能潛伏著李斯特菌、沙門氏菌等致命致病菌;灌溉水源若未經(jīng)嚴(yán)格處理,可能攜帶大腸桿菌和病毒;在原料的采摘、運輸和儲存過程中,運輸工具的清潔不徹底、溫濕度控制不當(dāng),極易造成交叉感染,將一顆“污染的種子”帶入生產(chǎn)大門。
生產(chǎn)端:滋生的“溫床”
生產(chǎn)車間是微生物污染風(fēng)險最集中、最復(fù)雜的環(huán)節(jié)。首先,環(huán)境控制是基礎(chǔ),車間溫濕度若失控,不僅會加速產(chǎn)品腐敗,更會為特定微生物(如霉菌)創(chuàng)造理想的生長環(huán)境。其次,設(shè)備是關(guān)鍵,生產(chǎn)線上的攪拌器、灌裝機、傳送帶縫隙、CIP(在線清洗)系統(tǒng)死角等,因結(jié)構(gòu)復(fù)雜或清潔難度大,極易形成生物膜,成為持續(xù)不斷的污染源。最后,人是最大的變量,操作人員不規(guī)范的個人衛(wèi)生、不按SOP(標(biāo)準(zhǔn)操作程序)作業(yè)、隨意走動帶來的交叉污染,都是導(dǎo)致防線崩潰的常見原因。
儲運端:風(fēng)險的“放大器”
即便產(chǎn)品安全下線,儲運環(huán)節(jié)仍不可掉以輕心。包裝材料的密封性若存在微小瑕疵,或封口工藝不達標(biāo),就會為外界微生物提供入侵通道。倉儲環(huán)境與冷鏈物流中的溫濕度波動,更是二次污染的“放大器”,可能導(dǎo)致殘存的微生物大量繁殖,最終在消費者手中引發(fā)產(chǎn)品變質(zhì)甚至食源性疾病,如由沙門氏菌引起的急性腸胃炎,或由黃曲霉毒素等霉菌毒素導(dǎo)致的長期健康風(fēng)險,這直接威脅著消費者的生命健康,并對企業(yè)的品牌聲譽造成毀滅性打擊。
第二篇章:梵通生物解決方案——構(gòu)建科學(xué)、精準(zhǔn)、長效的生物安全防線
面對如此嚴(yán)峻復(fù)雜的挑戰(zhàn),零散、被動的消毒方式已無法滿足現(xiàn)代食品安全管理的需求。梵通生物提出了一套集“科學(xué)溯源、精準(zhǔn)干預(yù)、長效管控”于一體的閉環(huán)式解決方案。
Step 1:智能檢測,精準(zhǔn)鎖定污染源頭
亡羊補牢,不如未雨綢繆。我們首先通過先進的檢測技術(shù),變被動應(yīng)對為主動發(fā)現(xiàn)。
分子生物學(xué)技術(shù)溯源:我們摒棄了傳統(tǒng)培養(yǎng)法耗時長、靈敏度低的弊端,采用PCR(聚合酶鏈?zhǔn)椒磻?yīng))、基因測序等高敏分子生物學(xué)手段。這不僅能快速、精準(zhǔn)地識別出沙門氏菌、大腸桿菌O157:H7、李斯特菌等特定致病微生物的種類,還能對其進行定量分析,評估污染的嚴(yán)重程度。
三維環(huán)境采樣與熱力圖分析:我們的專業(yè)團隊會對生產(chǎn)環(huán)境進行立體式采樣,包括空氣中的沉降菌、設(shè)備表面的接觸碟、以及原料、半成品和成品的取樣。通過對海量數(shù)據(jù)的分析,我們能夠構(gòu)建出一張直觀的“污染熱力圖”,快速定位高風(fēng)險區(qū)域和主要污染源頭,為后續(xù)的精準(zhǔn)干預(yù)提供科學(xué)依據(jù)。
Step 2:定制化方案,全鏈路精準(zhǔn)消毒
鎖定源頭后,我們需“對癥下藥”,實施精準(zhǔn)打擊。
靶向消毒技術(shù)設(shè)計:根據(jù)溯源結(jié)果和污染微生物的類型,我們匹配最適宜的國際認(rèn)證消毒技術(shù)。例如,針對空間環(huán)境和復(fù)雜設(shè)備表面,我們推薦采用汽化過氧化氫(VHP)技術(shù),其氣體形態(tài)能實現(xiàn)無死角覆蓋,確保對細(xì)菌、芽孢、真菌和病毒達到99.99%甚至更高的滅菌率,且分解后無任何有毒殘留。
工藝流程優(yōu)化升級:消毒不僅是“用藥”,更是系統(tǒng)工程。我們協(xié)助企業(yè)改造車間氣流布局,建立合理的壓差梯度,防止污染擴散;我們制定詳盡、可執(zhí)行的標(biāo)準(zhǔn)化清潔SOP,并對員工進行系統(tǒng)培訓(xùn);我們還引入自動化消毒設(shè)備,如過氧化氫機器人,減少人為干預(yù),確保消毒效果的均一性和穩(wěn)定性,從根本上阻斷微生物的滋生環(huán)境。
Step 3:動態(tài)監(jiān)測,建立長效保障機制
一次性的成功不是終點,持續(xù)的安全才是目標(biāo)。我們通過數(shù)字化手段,建立長效保障機制。
數(shù)字化監(jiān)控平臺:我們?yōu)槠髽I(yè)部署集成了物聯(lián)網(wǎng)傳感器的數(shù)字化監(jiān)控平臺,實時監(jiān)測車間關(guān)鍵控制點的溫濕度、空氣壓力差、表面菌落數(shù)等核心指標(biāo)。一旦數(shù)據(jù)出現(xiàn)異常波動,系統(tǒng)將自動觸發(fā)預(yù)警機制,第一時間通知管理人員介入處理。
周期性復(fù)檢與策略調(diào)整:我們提供季度性的深度檢測服務(wù)和月度的現(xiàn)場巡檢服務(wù),定期評估防控體系的有效性。根據(jù)監(jiān)測數(shù)據(jù)和復(fù)檢結(jié)果,我們會動態(tài)調(diào)整消毒策略和SOP,形成一個持續(xù)改進的PDCA(計劃-執(zhí)行-檢查-行動)循環(huán),確保污染風(fēng)險永不反彈,為企業(yè)的長治久安提供堅實保障。
